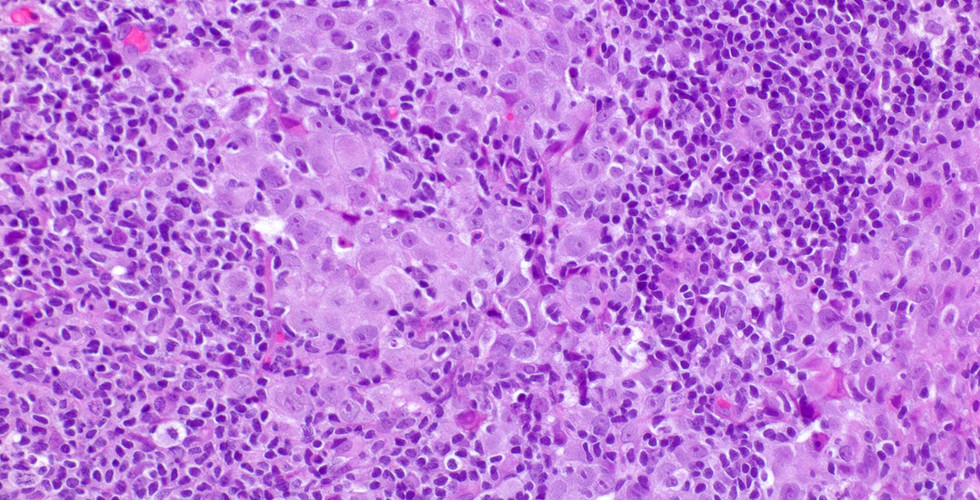

Case of the Week
- Elizabeth Montgomery, MD
- Oct 2, 2022
- 1 min read
Gastric carcinoma with lymphoid stroma (the WHO name), also termed lymphoepithelioma-like carcinoma. This one is EBV-driven, but the same pattern can be seen in MMR deficient gastric carcinoma (medullary type).
Case provided by Dr. Elizabeth Montgomery, Vice Chair of Faculty Development & Mentoring, Director of Surgical Pathology Fellowship Training Program, Co-Director, Pathology Reference Services, and Editor-In-Chief at Innovative Science Press.
You can check out our titles at:
www.innovativesciencepress.com nfo@innovativepathologypress.com 1-703-350-4308/703-340-3198 Fax: 1-855-661-7331

Wow